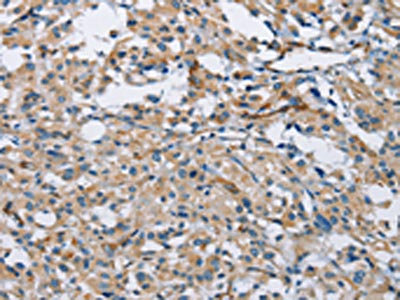

PTK6 Antibody
-
中文名稱:PTK6兔多克隆抗體
-
貨號:CSB-PA997274
-
規格:¥1100
-
圖片:
-
The image on the left is immunohistochemistry of paraffin-embedded Human thyroid cancer tissue using CSB-PA997274(PTK6 Antibody) at dilution 1/30, on the right is treated with fusion protein. (Original magnification: ×200)
-
The image on the left is immunohistochemistry of paraffin-embedded Human cervical cancer tissue using CSB-PA997274(PTK6 Antibody) at dilution 1/30, on the right is treated with fusion protein. (Original magnification: ×200)
-
-
其他:
產品詳情
-
Uniprot No.:
-
基因名:
-
別名:Breast tumor kinase antibody; Breast tumour kinase antibody; Protein tyrosine kinase 6 antibody; Protein-tyrosine kinase 6 antibody; Ptk6 antibody; PTK6_HUMAN antibody; Tyrosine protein kinase BRK antibody; Tyrosine-protein kinase BRK antibody
-
宿主:Rabbit
-
反應種屬:Human,Mouse
-
免疫原:Fusion protein of Human PTK6
-
免疫原種屬:Homo sapiens (Human)
-
標記方式:Non-conjugated
-
抗體亞型:IgG
-
純化方式:Antigen affinity purification
-
濃度:It differs from different batches. Please contact us to confirm it.
-
保存緩沖液:-20°C, pH7.4 PBS, 0.05% NaN3, 40% Glycerol
-
產品提供形式:Liquid
-
應用范圍:ELISA,IHC
-
推薦稀釋比:
Application Recommended Dilution ELISA 1:2000-1:5000 IHC 1:25-1:100 -
Protocols:
-
儲存條件:Upon receipt, store at -20°C or -80°C. Avoid repeated freeze.
-
貨期:Basically, we can dispatch the products out in 1-3 working days after receiving your orders. Delivery time maybe differs from different purchasing way or location, please kindly consult your local distributors for specific delivery time.
-
用途:For Research Use Only. Not for use in diagnostic or therapeutic procedures.
相關產品
靶點詳情
-
功能:Non-receptor tyrosine-protein kinase implicated in the regulation of a variety of signaling pathways that control the differentiation and maintenance of normal epithelia, as well as tumor growth. Function seems to be context dependent and differ depending on cell type, as well as its intracellular localization. A number of potential nuclear and cytoplasmic substrates have been identified. These include the RNA-binding proteins: KHDRBS1/SAM68, KHDRBS2/SLM1, KHDRBS3/SLM2 and SFPQ/PSF; transcription factors: STAT3 and STAT5A/B and a variety of signaling molecules: ARHGAP35/p190RhoGAP, PXN/paxillin, BTK/ATK, STAP2/BKS. Associates also with a variety of proteins that are likely upstream of PTK6 in various signaling pathways, or for which PTK6 may play an adapter-like role. These proteins include ADAM15, EGFR, ERBB2, ERBB3 and IRS4. In normal or non-tumorigenic tissues, PTK6 promotes cellular differentiation and apoptosis. In tumors PTK6 contributes to cancer progression by sensitizing cells to mitogenic signals and enhancing proliferation, anchorage-independent survival and migration/invasion. Association with EGFR, ERBB2, ERBB3 may contribute to mammary tumor development and growth through enhancement of EGF-induced signaling via BTK/AKT and PI3 kinase. Contributes to migration and proliferation by contributing to EGF-mediated phosphorylation of ARHGAP35/p190RhoGAP, which promotes association with RASA1/p120RasGAP, inactivating RhoA while activating RAS. EGF stimulation resulted in phosphorylation of PNX/Paxillin by PTK6 and activation of RAC1 via CRK/CrKII, thereby promoting migration and invasion. PTK6 activates STAT3 and STAT5B to promote proliferation. Nuclear PTK6 may be important for regulating growth in normal epithelia, while cytoplasmic PTK6 might activate oncogenic signaling pathways.; Isoform 2 inhibits PTK6 phosphorylation and PTK6 association with other tyrosine-phosphorylated proteins.
-
基因功能參考文獻:
- Using small molecule inhibitors, findings suggest that the kinase activity of PTK6 does not play a significant role in breast tumorigenesis. PMID: 29879184
- These results indicate that plasma-membrane-associated PTK6 phosphorylates Eps8, which promotes cell proliferation, adhesion, and migration PMID: 28214294
- Expression of PTK6 in established tumors may maintain the epithelial phenotype, preventing tumor progression. PMID: 26983689
- analysis of recombinant PTK6 kinase domain by x-ray crystallography reveals details of its binding to inhibitors PMID: 27993680
- The crystal structure of the kinase domain of human PTK6 has been reported. PMID: 27480927
- PTK6 mRNA and protein levels were elevated in cervical squamous cell cancer and the elevated cytoplasmic expression of PTK6 was associated with tumor grade and short patient survival. PMID: 27311570
- PELP1 interacted with GR to activate Brk expression. PMID: 26825173
- PTK6 prolongs S-phase and increases the ability of gemcitabine to cause DNA damage in vitro and in vivo PMID: 26013168
- BRK expression in a majority of CC can interact with RTK, augmenting growth and interfering with proliferation inhibitors (SAM68). Therapeutically targeting BRK function (in addition to RTK) should be of benefit for CC treatment. PMID: 25770659
- Additive impact of HER2-/PTK6-RNAi on interactions with HER3 or IGF-1R leads to reduced breast cancer progression PMID: 25241146
- Establishment of cross talk between PTK6 and CagA by functional studies may further elucidate the underlying biology of H. pylori-mediated gastric cancer PMID: 25838168
- PTK6 is expressed in the normal human mammary gland, but does not appear to be active and may have kinase-independent functions that are distinct from its cancer promoting activities at the membrane. PMID: 25153721
- Down-regulated expression of PTK6 is correlated with poor survival in esophageal squamous cell carcinoma. PMID: 25377660
- PTP1B inhibited BRK by dephosphorylating Tyr-342, but activated SRC by antagonizing PAG-dependent inhibition by CSK. PMID: 25897081
- Activating mutations in BRK in breast cancer may disrupt intramolecular interactions that normally maintain BRK in an autoinhibited conformation. PMID: 25940761
- This study shows that Brk phosphorylates p27KIP1, regulating the activity of cyclin D-cyclin-dependent kinase 4. PMID: 25733683
- Hypoxia-induced PTK6 stabilization and subcellular re-localization to the plasma membrane include increased cell motility and invasion, suggesting PTK6 targeting as a therapeutic approach to reduce hypoxia-regulated metastatic potential. PMID: 25019382
- PTK6 regulates cellular migration and invasion in pancreatic cancer via ERK signaling. PTK6 may be a novel therapeutic target for pancreatic cancer. PMID: 24788754
- BRK has a role in targeting Dok1 for ubiquitin-mediated proteasomal degradation and in promoting cell proliferation and migration PMID: 24523872
- Degradation of Brk involved a calpain-1-mediated proteolytic pathway and indicated an inverse relationship between the level of HER2 expression and calpain-1 activity. PMID: 23707532
- Protein tyrosine kinase 6 may have a role in poor prognosis and metastasis of nasopharyngeal carcinoma PMID: 23758975
- Highly active PTK6 promoted epithelial-mesenchymal transition by enhancing activation of AKT, thereby stimulating cancer cell migration and metastases in xenograft models of prostate cancer. PMID: 23856248
- High PTK6 expression is associated with hypoxia-associated breast cancer progression. PMID: 23928995
- an important role for PTP1B as a negative regulator of BRK and IGF-1Rbeta signaling in ovarian cancer cells. PMID: 23814047
- Protein tyrosine kinase 6 protects cells from anoikis by directly phosphorylating focal adhesion kinase and activating AKT. PMID: 23027128
- Brk/PTK6 cooperates with HER2 and Src in regulating breast cancer cell survival and epithelial-to-mesenchymal transition. PMID: 23291984
- present findings indicated that cytoplasmic PTK6 expression is a potential prognostic factor for survival in LSCC patients. High expression of PTK6 was associated with favorable OS and DFS in LSCC patients PMID: 23497344
- These results provide evidence for a novel mechanism demonstrating the oncogenic potential of PTK6 through degradation of c-Cbl, which is an E3 ligase important in down-regulation of oncoproteins. PMID: 23352614
- Knockdown of PTK6 enhances apoptosis in HCT116 cells with wild-type p53. PMID: 22989419
- breast tumor kinase (Brk)/protein-tyrosine kinase 6 (PTK6), a nonreceptor protein-tyrosine kinase highly expressed in most human breast tumors, interacted with EGFR and sustained ligand-induced EGFR signaling. PMID: 22231447
- Brk expression in human breast tumors may contribute to progression by inducing p38-driven pro-survival signaling pathways. PMID: 21923922
- results demonstrate that Hsp90 plays an essential role in regulating PTK6 stability and suggest that Hsp90 inhibitors may be useful as therapeutic drugs for PTK6-positive cancers, including breast cancer PMID: 22849407
- PTK6 was identified as a transcript that is down-regulated in human esophageal squamous cell carcinoma via epigenetic modification at the PTK6 locus. PMID: 22705009
- Suppressor of cytokine signaling 3 inhibits breast tumor kinase activation of STAT3. PMID: 22547065
- a novel function for PTK6 at the plasma membrane PMID: 22084245
- show that as primary human keratinocytes are induced to differentiate in vitro, Brk levels decrease PMID: 21240512
- present findings indicate an increase of cytoplasmic Brk expression in non-small cell lung cancer PMID: 21603980
- Data suggest that since PTK6 plays an important role in HER receptor signal transduction, its down-regulation might be suitable for future therapy approaches in breast cancer. PMID: 21380407
- Alternative transcript-PTK6 is able to negatively regulate growth and modulate PTK6 activity, protein-protein associations and/or subcellular localization. PMID: 21479203
- Interactions of STAP-2 with Brk and STAT3 participate in cell growth of human breast cancer cells. PMID: 20929863
- Brk antagonizes the transcriptional activity of the transcription factor FoxO family of proteins by inhibiting its nuclear localization. As a result, the cell cycle inhibitor p27, a FoxO target gene, is down-regulated. PMID: 20162673
- PTK6 enhances EGFR signaling by inhibition of EGFR down-regulation through phosphorylation of ARAP1 in breast cancer cells. PMID: 20554524
- AKT is a direct substrate of PTK6 and AKT tyrosine residues 315 and 326 are phosphorylated by PTK6. PMID: 20606012
- PTK6 associates with nuclear and cytoplasmic beta-catenin and inhibits beta-catenin- and T-cell factor (TCF)-mediated transcription. PMID: 20026641
- the effect of Sam68 was inhibited in a dose-dependent manner by coexpression of an activated form of the nuclear kinase Sik/BRK that hyperphosphorylated Sam68 PMID: 12482964
- The tyrosine kinases Brk/PTK6/Sik, Srm, Frk/Rak/Gtk/Iyk/Bsk, and Src42A/Dsrc41 have a low degree of sequence homology to other known kinases. The exon structure of these kinases, called the Brk family, is highly conserved and distinct. PMID: 12725532
- BRK plays a role in differentiation of prostate epithelial cells PMID: 12833144
- Study suggests that SH3 interactions will govern phosphorylation of many substrates by BRK. PMID: 14676834
- Results describe the solution structure and backbone dynamics of the human protein-tyrosine kinase-6 Src homology 2 (SH2) domain using multidimensional NMR spectroscopy. PMID: 15056653
- in breast cancer cells breast tumor kinase (Brk) behaves similarly to a constitutively active Brk mutant (YF-Brk) and associates with tyrosine-phosphorylated proteins in deregulated signaling complexes PMID: 15539407
顯示更多
收起更多
-
亞細胞定位:Cytoplasm. Nucleus. Cell projection, ruffle. Membrane. Note=Colocalizes with KHDRBS1, KHDRBS2 or KHDRBS3, within the nucleus. Nuclear localization in epithelial cells of normal prostate but cytoplasmic localization in cancer prostate.
-
蛋白家族:Protein kinase superfamily, Tyr protein kinase family, BRK/PTK6/SIK subfamily
-
組織特異性:Epithelia-specific. Very high level in colon and high levels in small intestine and prostate, and low levels in some fetal tissues. Not expressed in breast or ovarian tissue but expressed in high percentage of breast and ovarian cancers. Also overexpresse
-
數據庫鏈接:
Most popular with customers
-
YWHAB Recombinant Monoclonal Antibody
Applications: ELISA, WB, IHC, IF, FC
Species Reactivity: Human, Mouse, Rat
-
Phospho-YAP1 (S127) Recombinant Monoclonal Antibody
Applications: ELISA, WB, IHC
Species Reactivity: Human
-
-
-
-
-
-